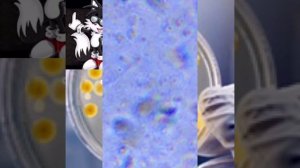
Неизвестные бактерии под микроскопом

29:05
29:05
2024-09-26 12:57

 2:09
2:09
2:09
2:09
2024-10-24 19:36

 26:01
26:01

 26:01
26:01
2024-09-26 19:17
![ДАР УБЕЖДЕНИЯ | НАДЕЖДА СЫСОЕВА]() 49:20
49:20
 49:20
49:20
2024-10-02 17:03

 1:32:37
1:32:37

 1:32:37
1:32:37
2024-11-28 13:51

 2:21:03
2:21:03

 2:21:03
2:21:03
2024-09-29 21:40

 2:02:01
2:02:01

 2:02:01
2:02:01
2024-09-29 23:00

 46:36
46:36

 46:36
46:36
2024-09-27 18:09

 1:05:04
1:05:04

 1:05:04
1:05:04
2024-09-30 22:40

 49:51
49:51

 49:51
49:51
2024-10-02 15:57

 27:00
27:00

 27:00
27:00
2024-10-01 01:30

 0:54
0:54

 0:54
0:54
2023-09-13 10:43

 58:46
58:46

 58:46
58:46
2024-09-27 18:00

 39:25
39:25

 39:25
39:25
2024-09-27 15:00

 1:14:48
1:14:48

 1:14:48
1:14:48
2024-10-02 15:00

 32:07
32:07

 32:07
32:07
2024-09-30 15:00

 54:23
54:23

 54:23
54:23
2024-09-28 15:18

 45:46
45:46
![Джатдай - Забери печаль (Премьера клипа 2025)]() 2:29
2:29
![Илёс Юнусий - Каранг она якинларим (Премьера клипа 2025)]() 3:36
3:36
![SERYABKINA, Брутто - Светофоры (Премьера клипа 2025)]() 3:49
3:49
![ESCO - За тобой (Премьера клипа 2025)]() 2:13
2:13
![Selena Gomez - In The Dark (Official Video 2025)]() 3:04
3:04
![Бобур Ахмад - Куролмаслар (Премьера клипа 2025)]() 3:33
3:33
![Светлана Ларионова - Осень отстой (Премьера клипа 2025)]() 3:30
3:30
![ARTIX - Ай, джана-джана (Премьера клипа 2025)]() 2:24
2:24
![Сергей Завьялов - В дороге (Премьера клипа 2025)]() 3:14
3:14
![A'Studio – Она не виновата (Премьера клипа 2025)]() 2:13
2:13
![KhaliF - Где бы не был я (Премьера клипа 2025)]() 2:53
2:53
![Мухит Бобоев - Маликам (Премьера клипа 2025)]() 3:18
3:18
![Сардор Расулов - Етолмадим (Премьера клипа 2025)]() 4:15
4:15
![Bruno Mars ft. Ed Sheeran – Home to You (Official Video 2025)]() 3:25
3:25
![Шерзодбек Жонибеков - Дадажон (Премьера клипа 2025)]() 3:02
3:02
![Tural Everest - Ночной город (Премьера клипа 2025)]() 3:00
3:00
![Сергей Одинцов - Девочка любимая (Премьера клипа 2025)]() 3:56
3:56
![Иброхим Уткиров - Коракуз (Премьера клипа 2025)]() 4:28
4:28
![Рустам Нахушев, Зульфия Чотчаева - Каюсь (Премьера клипа 2025)]() 3:20
3:20
![Инна Вальтер - Роза (Премьера клипа 2025)]() 3:18
3:18
![Супруги Роуз | The Roses (2025)]() 1:45:29
1:45:29
![Заклятие 4: Последний обряд | The Conjuring: Last Rites (2025)]() 2:15:54
2:15:54
![Чумовая пятница 2 | Freakier Friday (2025)]() 1:50:38
1:50:38
![Дикари | The Savages (2007)]() 1:54:19
1:54:19
![Элис, дорогая | Alice, Darling (2022)]() 1:29:30
1:29:30
![Пойман с поличным | Caught Stealing (2025)]() 1:46:45
1:46:45
![Мужчина у меня в подвале | The Man in My Basement (2025)]() 1:54:48
1:54:48
![Порочный круг | Vicious (2025)]() 1:42:30
1:42:30
![Псы войны | Hounds of War (2024)]() 1:34:38
1:34:38
![Непрощённая | The Unforgivable (2021)]() 1:54:10
1:54:10
![Сумерки | Twilight (2008)]() 2:01:55
2:01:55
![Когда ты закончишь спасать мир | When You Finish Saving the World (2022)]() 1:27:40
1:27:40
![Голос любви | Aline (2020)]() 2:05:43
2:05:43
![Плохой Cанта 2 | Bad Santa 2 (2016) (Гоблин)]() 1:28:32
1:28:32
![Баллада о маленьком игроке | Ballad of a Small Player (2025)]() 1:42:60
1:42:60
![Плюшевый пузырь | The Beanie Bubble (2023)]() 1:50:15
1:50:15
![Лос-Анджелес в огне | Kings (2017)]() 1:29:27
1:29:27
![Хищник | Predator (1987) (Гоблин)]() 1:46:40
1:46:40
![Храброе сердце | Braveheart (1995)]() 2:57:46
2:57:46
![Лучшее Рождество! | Nativity! (2009)]() 1:46:00
1:46:00
![Космический рейнджер Роджер Сезон 1]() 11:32
11:32
![Команда Дино Сезон 2]() 12:31
12:31
![Сборники «Простоквашино»]() 1:05:35
1:05:35
![Роботы-пожарные]() 12:31
12:31
![Котёнок Шмяк]() 11:04
11:04
![Корги по имени Моко. Защитники планеты]() 4:33
4:33
![Корги по имени Моко. Новый питомец]() 3:28
3:28
![Отряд А. Игрушки-спасатели]() 13:06
13:06
![Поймай Тинипин! Королевство эмоций]() 12:24
12:24
![Кадеты Баданаму Сезон 1]() 11:50
11:50
![Новогодние мультики – Союзмультфильм]() 7:04
7:04
![Шахерезада. Нерассказанные истории Сезон 1]() 23:53
23:53
![МегаМен: Полный заряд Сезон 1]() 10:42
10:42
![Команда Дино Сезон 1]() 12:08
12:08
![Супер Зак]() 11:38
11:38
![Последний книжный магазин]() 11:20
11:20
![Енотки]() 7:04
7:04
![Новое ПРОСТОКВАШИНО]() 6:30
6:30
![Оранжевая корова]() 6:30
6:30
![Сборники «Приключения Пети и Волка»]() 1:50:38
1:50:38

 45:46
45:46Скачать видео
| 256x144 | ||
| 426x240 | ||
| 640x360 | ||
| 854x480 | ||
| 1280x720 | ||
| 1920x1080 |
 2:29
2:29
2025-10-24 11:25
 3:36
3:36
2025-11-02 10:25
 3:49
3:49
2025-10-25 12:52
 2:13
2:13
2025-10-31 12:20
 3:04
3:04
2025-10-24 11:30
 3:33
3:33
2025-11-02 10:17
 3:30
3:30
2025-10-24 11:42
 2:24
2:24
2025-10-28 12:09
 3:14
3:14
2025-10-29 10:28
 2:13
2:13
2025-10-31 12:53
 2:53
2:53
2025-10-28 12:16
 3:18
3:18
2025-11-02 10:30
 4:15
4:15
2025-10-26 12:52
 3:25
3:25
2025-11-02 10:34
 3:02
3:02
2025-10-25 13:03
 3:00
3:00
2025-10-28 11:50
 3:56
3:56
2025-10-28 11:02
 4:28
4:28
2025-11-03 15:38
 3:20
3:20
2025-10-30 10:39
 3:18
3:18
2025-10-28 10:36
0/0
 1:45:29
1:45:29
2025-10-23 18:26
 2:15:54
2:15:54
2025-10-13 19:02
 1:50:38
1:50:38
2025-10-16 16:08
 1:54:19
1:54:19
2025-08-27 18:01
 1:29:30
1:29:30
2025-09-11 08:20
 1:46:45
1:46:45
2025-10-02 20:45
 1:54:48
1:54:48
2025-10-01 15:17
 1:42:30
1:42:30
2025-10-14 20:27
 1:34:38
1:34:38
2025-08-28 15:32
 1:54:10
1:54:10
2025-08-27 17:17
 2:01:55
2:01:55
2025-08-28 15:32
 1:27:40
1:27:40
2025-08-27 17:17
 2:05:43
2:05:43
2025-08-27 18:01
 1:28:32
1:28:32
2025-10-07 09:27
 1:42:60
1:42:60
2025-10-31 10:53
 1:50:15
1:50:15
2025-08-27 18:32
 1:29:27
1:29:27
2025-08-28 15:32
 1:46:40
1:46:40
2025-10-07 09:27
 2:57:46
2:57:46
2025-08-31 01:03
 1:46:00
1:46:00
2025-08-27 17:17
0/0
2021-09-22 21:49
2021-09-22 22:40
 1:05:35
1:05:35
2025-10-31 17:03
2021-09-23 00:12
 11:04
11:04
2023-05-18 16:41
 4:33
4:33
2024-12-17 16:56
 3:28
3:28
2025-01-09 17:01
 13:06
13:06
2024-11-28 16:30
 12:24
12:24
2024-11-27 13:24
2021-09-22 21:17
 7:04
7:04
2023-07-25 00:09
2021-09-22 23:25
2021-09-22 21:43
2021-09-22 22:29
2021-09-22 22:07
 11:20
11:20
2025-09-12 10:05
 7:04
7:04
2022-03-29 18:22
 6:30
6:30
2018-04-03 10:35
 6:30
6:30
2022-03-31 18:49
 1:50:38
1:50:38
2025-10-29 16:37
0/0

